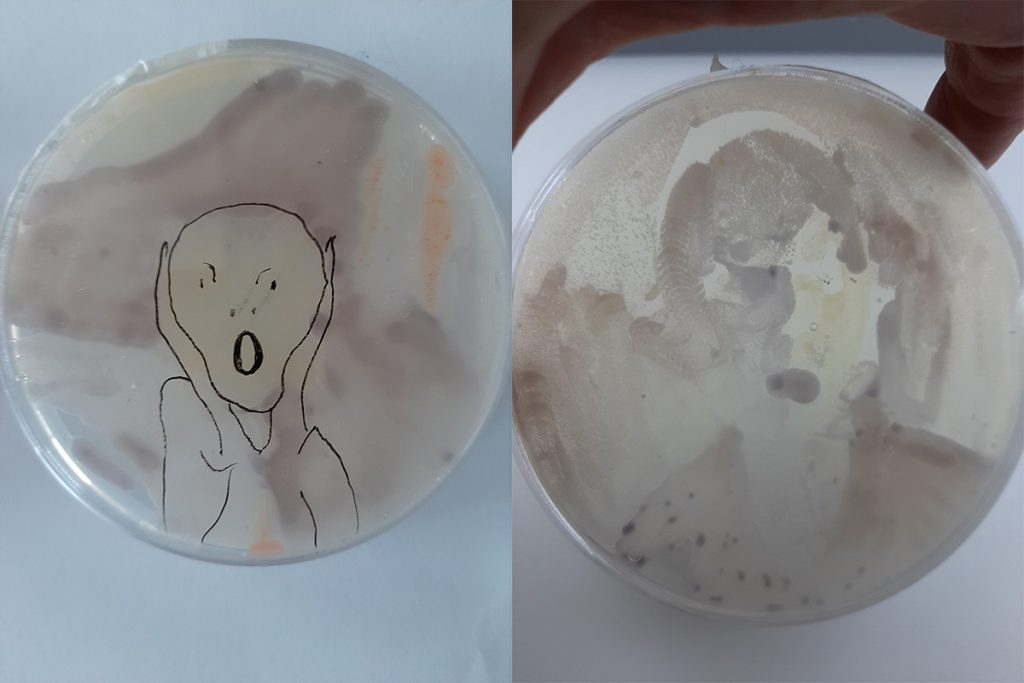
Hankkeen aikana tehtyä bakteeritaidetta.

Kansalaistiede tarjoaa lukiolaisille mahdollisuuden osallistua tieteelliseen tutkimusprojektiin. Yhteistyö seitsemän lukion ja Jyväskylän yliopiston välillä Jaettu valo -hankkeessa ei rajoitu vain aineistokeruuseen, vaan vuorovaikutus sukeltaa paljon syvemmälle.
Kansalaistieteen (englanniksi citizen science) käsitteellä tarkoitetaan osin tai kokonaan maallikoiden tekemää tieteellistä tutkimusta. Kansalaisia voidaan esimerkiksi ottaa mukaan keräämään analysoitavaa aineistoa. Määritelmästään huolimatta kansalaistieteen ei tulisi olla vain tapa joukkoistaa aineistonkeruuta, vaan enemmänkin vuorovaikutteinen prosessi kansalaisten ja tutkijoiden kesken.
Jaettu valo -hankkeessa hyödynnetään kansalaistieteen menetelmiä, kun tutkimukseen osallistuvien lukioiden opiskelijat keräävät näytteitä oman koulunsa lähimetsästä. Hankkeessa kouluyhteistyötä koordinoivan Kati Heikkilä-Huhdan mukaan lukiolaisten rooli ei rajoitu tähän.
– Aineiston keruun lisäksi lukiolaisilla on ollut mahdollisuus syventyä aiheeseen opinnoissaan enemmänkin. Esimerkiksi Kerttulin lukiossa Turussa yhteistyö on kytketty valinnaiseen kurssiin. Aiheeseen perehtyneet opiskelijat pääsivät esittämään tutkijoille hienoja kysymyksiä ensimmäisen lukuvuoden huipentaneessa seminaarissa, kertoo Heikkilä-Huhta.

Yhteistyö hyödyttää molempia osapuolia
Osallistuminen tutkimusprosessiin antaa lukiolaisille väläyksen siitä, mitä tiede todellisuudessa on ja mitä kaikkea sen tekemiseen liittyy. Yliopistolle yhteistyö koulujen kanssa antaa esimerkiksi mahdollisuuden kerätä tutkimusaineistoa tavoilla, jotka eivät muuten olisi mahdollisia. Lisäksi se on tapa vaikuttaa ympäröivän yhteiskunnan kanssa ja tehdä tutkimuksen tuloksia näkyväksi.
Heikkilä-Huhta kiittelee yhteistyön olevan hedelmällistä lukiolaisten kannalta.
– Työskentely on todella motivoivaa myös nuorten kannalta, he hoksaavat olevansa uuden tiedon äärellä. Näytteiden keruun lisäksi mahdollisuus opiskella maastossa on innostanut heitä. Tarkempi syventyminen tutkimukseen on suorastaan vienyt mukanaan.
Teeman puitteissa on myös kehitetty erilaisia oppimisprojekteja. Jyväskylän lyseon lukiossa kehitettiin aiheeseen liittyvä opintokokonaisuus, joka yhdistelee fysiikkaa, kuvataidetta ja biologiaa. Oppimisprojekti huipentui viikonloppuleirillä ja sitä on tarkoitus edelleen kehittää tuleville vuosille. Mikäli kurssin suorittaneet opiskelijat hakeutuvat myöhemmin Jyväskylän yliopistoon opiskelemaan, saavat se kaksi opintopistettä nanotiedeopintoihinsa.
Bakteereista syntyy eläviä taideteoksia
Näytteiden keräämisen lisäksi osallistuvilla lukioilla on mahdollisuus tarkastella bakteerimalleja kuvantamislaitteilla. Laitteen avulla opiskelijoille hahmottuu näkyvän valon ja infrapunavalon valon ominaisuuksia, mikä tukee saumattomasti fysiikan lukion oppimäärää. 3D-tulostuksen avulla valmistetut kuvantamislaitteet on annettu projektiin osallistuvien koulujen käyttöön. Parhaillaan selvitetään, onko laitteita mahdollista lainata tai myydä muillekin kouluille.
Tieteellisen ulottuvuuden lisäksi hankkeessa on myös taiteellinen ulottuvuus: taiteen keinoin tarkastellaan näkyvää ja näkymätöntä valoa ja sitä, miten valo toimii pohjoisen ekosysteemien rytmittäjänä. Lukioita kannustetaan ottamaan taiteellinen ulottuvuus mukaan opetukseensa.
– Teimme viime keväänä bakteerimaaleilla kokeiluja. Teoksissa maaleina toimivat elävät bakteeriviljelmät, jotka elatusainemaljalla kasvaessaan muodostavat elävän, kehittyvän taideteoksen. Bakteerimaalausta on värien lisäksi tehty painelemalla lehtiä agarpinnalle. Toiveenamme on, että koulujen olisi tulevaisuudessa mahdollista varata myös pelkkiä bakteerimaaleja käyttöönsä, kertoo Heikkilä-Huhta.
Kenttätyöskentely vaatii aikaa
Itsekin opettajana hankkeeseen osallistuva Heikkilä-Huhta nimeää suurimmaksi haasteeksi rajallisen ajan.
– Suurin haaste on löytää aikaa tällaiselle työskentelylle, kun lukion opetussuunnitelmat ovat niin täysiä. Se voi tarkoittaa esimerkiksi sitä, että jotain muuta opetettavaa sisältöä on jätettävä pois tai osallistumista projektiin rajoitettava. Olemme kuitenkin halunneet tehdä osallistumisen lukioille mahdollisimman helpoksi: näytteiden keruu on tärkeintä ja muita asioita voi tehdä halutessaan ja ehtiessään. Tästä huolimatta työskentely on ollut niin antoisaa, että ainakaan minun ei tarvinnut juurikaan punnita osallistumista.
Uuden aiheen tutkimuksen parissa työskentely on Heikkilä-Huhdan mukaan hedelmällistä siitä syystä, että prosessissa opettaja on yhtä lailla uuden edessä. Silloin on hyvä myöntää avoimesti oman tiedon rajat oppilailleen.
– Työskentelyssä parasta on ollut tarjota opettajille vinkkejä aiheen käsittelyyn ja katsoa sitten, miten he ovat innostuneet itse ja ottaneet aiheen omakseen. Uskon että tällöin löytyvät ne parhaat työtavat ja projektit, jotka sopivat juuri omalle ryhmälle, Heikki-Huhta mainitsee.
Jaettu valo -projekti syventyy luonnosta löytyviin bakteereihin
Jaettu valo -projektissa tutkitaan kasvien valoaktiivisia mikrobikumppaneita. Näitä valoaktiivisia bakteereita on aiemmin havaittu vesiympäristöistä, mutta viime vuosina myös kasvien lehdistä. Ne hyödyntävät sellaisia valon aallonpituuksia, joita isäntäkasvinsa eivät hyödynnä. Projektin tavoitteena on saada lisää tietoa näiden mikrobikumppaneiden levinneisyydestä ja toiminnasta. On muun muassa arveltu, että mikrobeilla saattaa olla vaikutusta kasvien toimintoihin ja stressinsietokykyyn pohjoisessa ilmastossa.
Lue lisää
- Haluaisitko oppia lisää kansalaistieteestä? Luonto oppimisympäristönä -kurssillamme käsitellään kansalaistiedettä kouluyhteistyön näkökulmasta.
Teksti: Jasmin Kopra Kuva: Otaniemen lukiolaisia keräämässä näytteitä projektia varten.